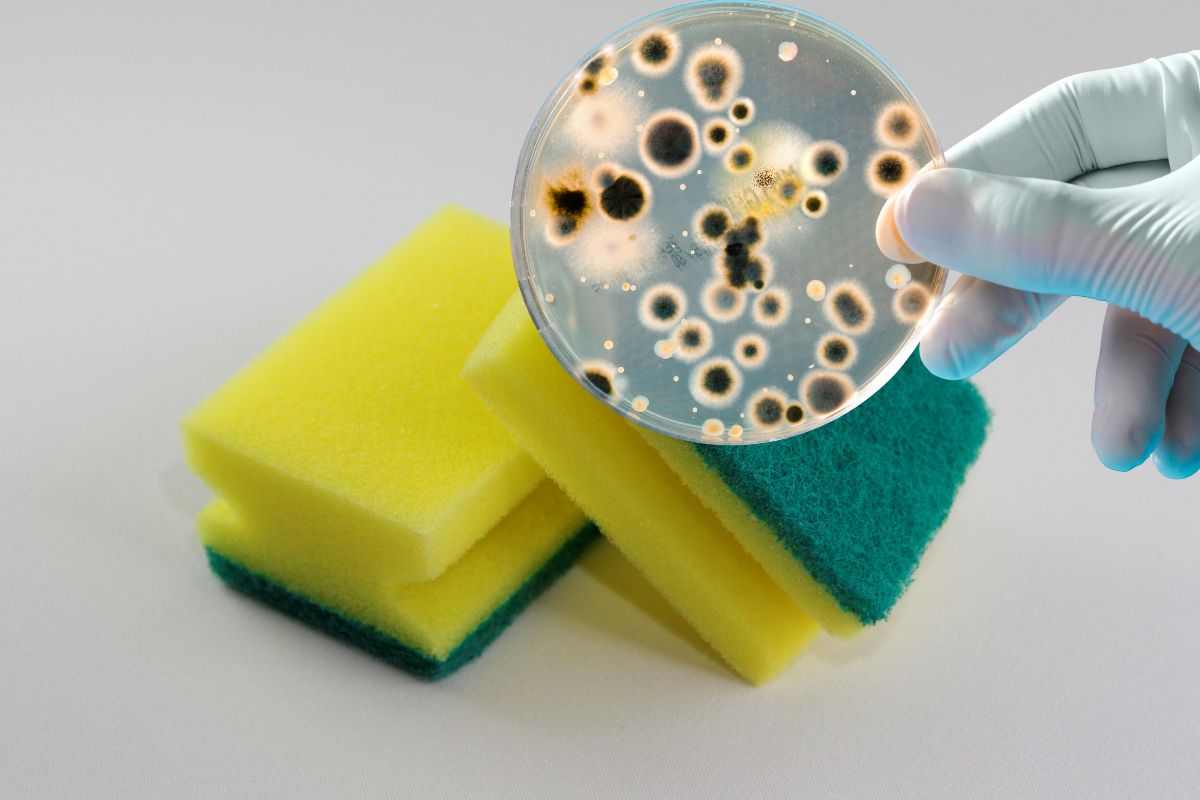
E’ l’oggetto più sporco della casa e ci pulisci piatti e stoviglie: come pulire correttamente la spugnetta per evitare conseguenze sulla salute

Allerta Escherichia coli: questi sono i cibi più a rischio di contaminazione, attenzione alla tua spesa
1 Novembre 2025
Attenzione alla spesa: in arrivo l’Allerta Escherichia coli, scopri quali sono i cibi più a rischio di contaminazione e come evitare rischi per la tua salute e quella della tua
Wine & Food
Wine & Food
Allerta Escherichia coli: questi sono i cibi più a rischio di contaminazione, attenzione alla tua spesa

Wine & Food
No, nemmeno tu sai qual è la temperatura giusta per cuocere un hamburger: se non la raggiungi rischi Salmonella o Escherichia Coli

Wine & Food
Scommetto che questo trucco nemmeno tu lo sapevi: sono un fruttivendolo e ti svelo come mantenere le banane gialle più a lungo possibile

Wine & Food
Mi era avanzato del pane e non volevo buttarlo: mia madre mi ha salvato, senza il suo consiglio avrei intossicato tutta la famiglia

Pulizia Perfetta
Pulizia perfetta
Hai in casa taglieri in plastica? Fai attenzione, solo se li lavi a questa temperatura annienti tutti i batteri

Pulizia perfetta
E’ l’oggetto più sporco della casa e ci pulisci piatti e stoviglie: come pulire correttamente la spugnetta per evitare conseguenze sulla salute
Pulizia perfetta
Avevo la cucina invasa dai moscerini: cerca bene in questo elettrodomestico, io mi stavo intossicando ogni giorno senza saperlo

Notizie

In questo oggetto della cucina ci sono 360milioni di batteri per centimetro quadrato: è peggio di un WC, come metterti in salvo

È stata più volte l’auto dell’anno, e la casa francese vuole puntarci ancora: appena presentata

Riforma pensioni: blocco dell’età pensionabile, ma solo per una categoria di lavoratori

Il rancore diventa veleno tra le due conduttrici a distanza di anni: il pubblico Rai è sconcertato

Nuovo amore per l’ex Grande Fratello: la foto del bacio diventa virale

